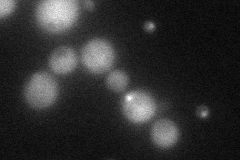
YGL108C
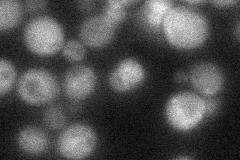
YGL108C
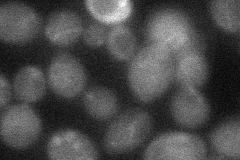
YGL108C
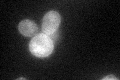
YGL108C
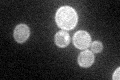
YGL108C

View description
Protein of unknown function, predicted to be palmitoylated; green fluorescent protein (GFP)-fusion protein localizes to the cell periphery
Localization:
Intensity:
Fold change:
Significance:
-
C’ GFP library in SD

cell periphery33.64 -
N' NOP1pr-GFP in SD
cytosol70.6192 -
N' TEF2pr-mCherry in SD

cytosol108.059 -
N' NATIVEpr-GFP in SD
cytosol30.5349 -
N' TEF2pr-VC and Cyto-VN in SD
cytosol33.0952 -
C’ GFP library in SD+DTT
cell periphery32.730.97No -
C’ GFP library in SD+H2O2

cell periphery26.870.79No -
C’ GFP library in Starvation Media
cell periphery54.731.62Yes -
C’ GFP library on the background of Pup2-DaMP

N/A -
C’ GFP library on the background of CCT mutant

N/A0N/AYes
